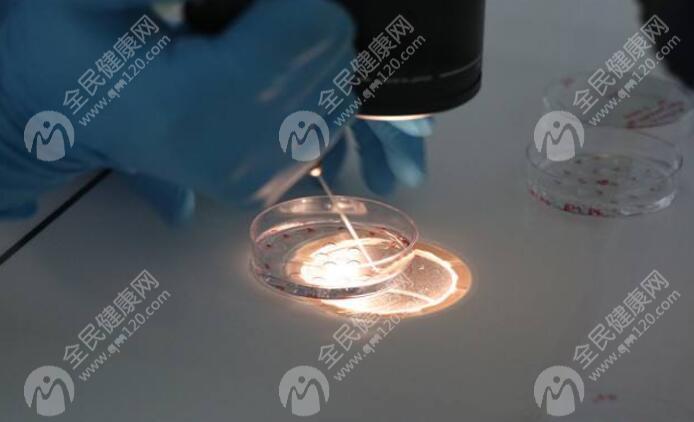

特别提示:接受试管婴儿技术的夫妇必须是合法夫妻,且仅限于治疗因特定不孕不育问题而无法通过其他方式怀孕的夫妇。
试管婴儿
时间: 2025-05-30 15:08:50
7人浏览
前往吉尔吉斯斯坦进行试管婴儿(IVF)治疗是一个需要充分准备和规划的过程。以下是一些关于如何安排相关事宜以及所需证照的信息,供您参考。
首先,出国进行医疗活动需要确保符合当地法律法规,并满足医疗机构的要求。对于计划在吉尔吉斯斯坦进行试管婴儿的家庭来说,以下几点是必须注意的:
1. 了解当地法规:在出发前,需确认吉尔吉斯斯坦对外国人进行试管婴儿的具体规定。例如,是否允许单亲或彩虹申请,以及是否有年龄限制等。
2. 国内 :同时也要了解国内对于公民在国外接受辅助生殖技术的相关 ,以避免回国后可能出现的问题。
为了顺利办理签证并完成治疗流程,通常需要准备以下文件:
1. 护照:有效期内的护照是出境的基本要求,建议至少有6个月以上的有效期。
2. 签证:根据目的地国家的规定申请旅游或医疗签证,部分情况下可能需要提供医院邀请函。
3. 结婚证明(如适用):如果是以夫妻身份共同参与治疗,则需携带婚姻关系证明。
4. 体检报告:包括双方的身体健康状况评估,特别是女性的卵巢功能和子宫环境检测结果。
5. 身份证件复印件:用于填写各种表格及备案使用。
6. 翻译件:所有非俄语或英语的文件都应准备好官方认可的翻译版本。
在决定前往之前,应该仔细挑选信誉良好的诊所或医院。可以通过查阅评价、咨询已体验过的患者来获取相关信息。此外,还应关注以下方面:
- 医院资质:确保其具备开展辅助生育服务的专业许可。
- 医生团队:了解主治医师的经验和技术水平。
- 成功率数据:对比不同机构的成功案例统计情况。
虽然不能提供具体数字,但一般而言,整个过程涉及的开销包括但不限于:
- 检查费
- 手术操作成本
- 药品支出
- 住宿交通等附加花费
因此,在做财务规划时要留出足够的余地应对可能出现的额外需求。
1. 语言沟通:考虑到文化差异,提前学习基础交流用语或者聘用专业翻译人员可能会更方便。
2. 保险覆盖:购买包含海外医疗服务项目的保险产品,以便在紧急状况下获得及时救助。
3. 心理准备:整个周期较长且充满不确定性,保持良好心态非常重要。
总之,去往吉尔吉斯斯坦实施试管计划是一项复杂但可行的选择。只要做好详尽的前期调查,并严格按照要求准备好各项资料,就能大大提高成功率。希望上述内容能够帮助到正在考虑这一选项的朋友!
扩展阅读
相关推荐
更多
城市导航
推荐阅读
更多
相关知识
广州三代试管价格多少?附费用明细
2025-10-01 06:04:53 · 8 人浏览
卵泡正常生长周期?卵泡正常发育速度对照表
2025-10-01 05:39:53 · 9 人浏览
2025年张家口市能做第三代试管婴儿的医院有哪些?能用社保报销吗?
2025-10-01 05:14:46 · 10 人浏览
有生完孩子后子宫腺肌症自己好了的例子吗?
2025-10-01 04:49:45 · 9 人浏览
广东做试管婴儿的花销大吗?费用大约多少?
2025-10-01 04:25:02 · 9 人浏览
2025年东莞市可以做试管婴儿的医院有哪些?费用纳入医保了吗?
2025-09-30 23:35:02 · 12 人浏览
备孕减肥不建议吃太多圣女果的原因是什么?
2025-09-30 23:09:41 · 10 人浏览
月经期间经量少且无不适症状可不可以同房?
2025-09-30 22:45:04 · 10 人浏览